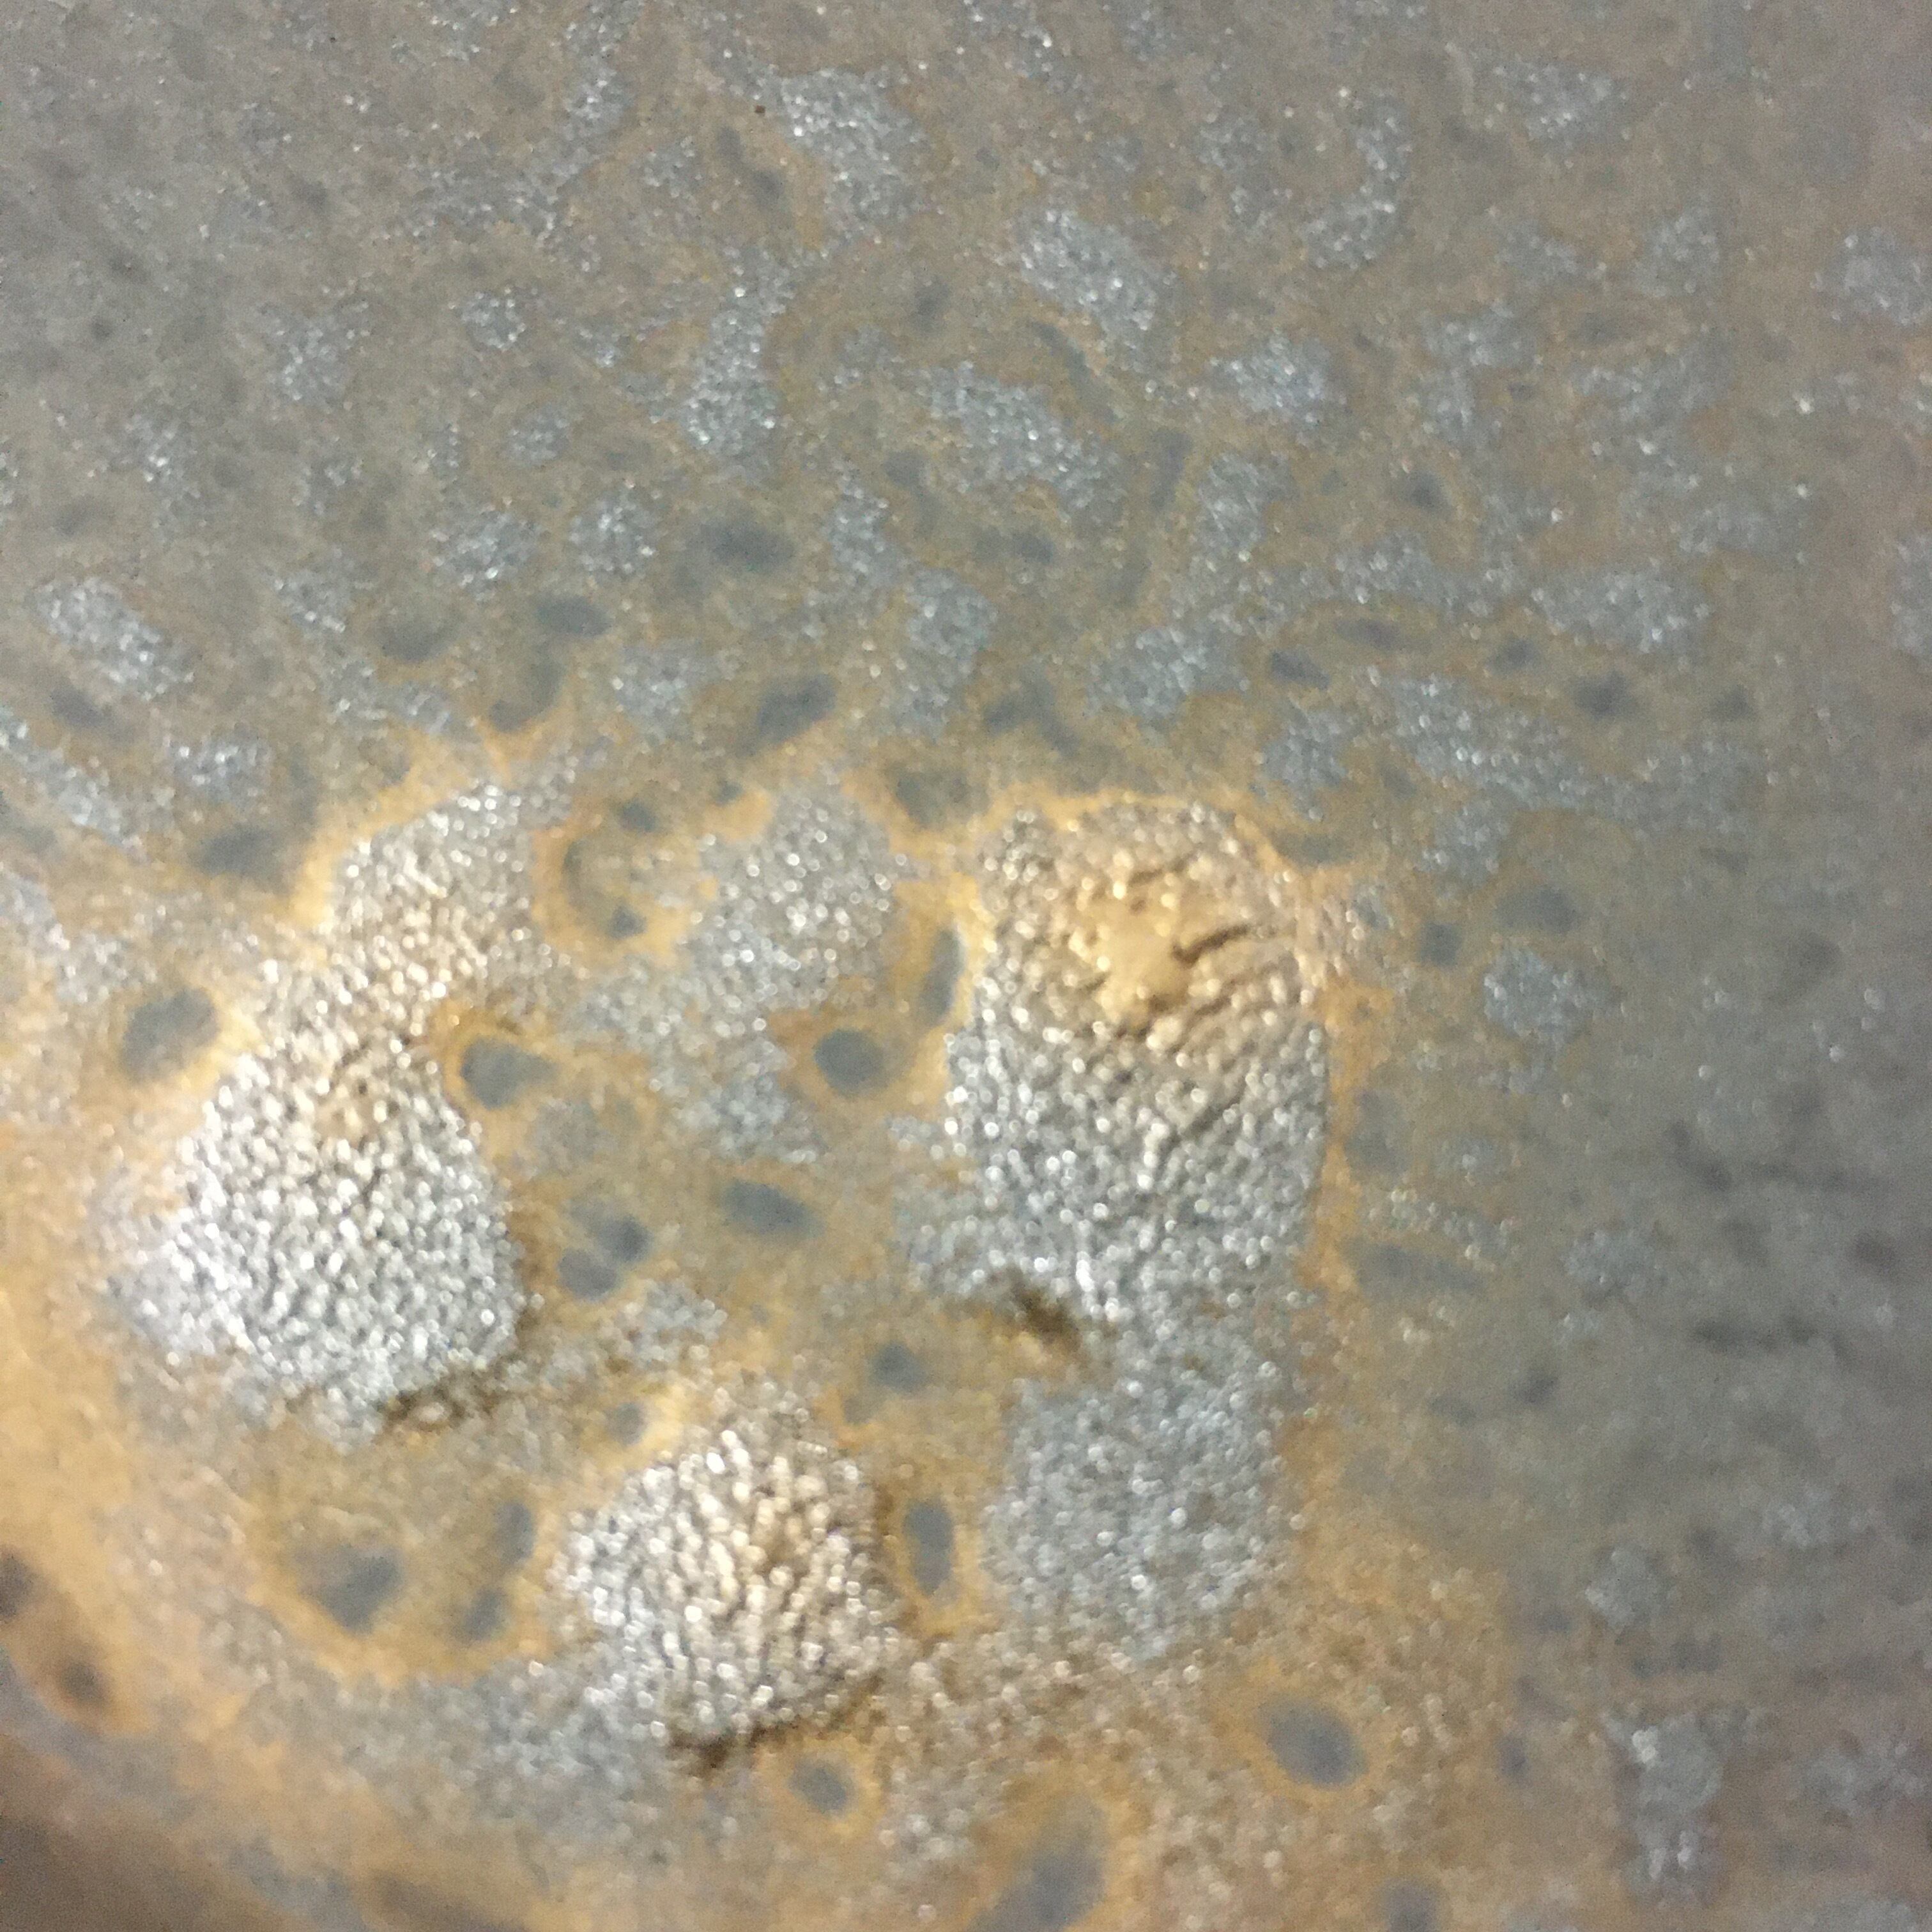

1/12
中皿
¥2,800
残り1点
International shipping available
釉薬は金彩マットです。
こちらのお皿は凹凸はありますが、さらさらとした肌触りになっています。
浮き出ている金模様は霧吹きで塗布しており、一枚一枚が異なる柄に仕上がっています。
サイズ
直径20cm、高さ2.2cm、重さ525g
6、7、8、9 、10、11、12枚目の商品写真はイメージです。
同一の釉薬を施した形の違うお皿のサンプル品を撮影しています。
最近チェックした商品
同じカテゴリの商品
その他の商品